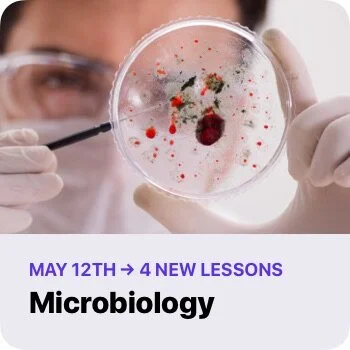

Tappity Content Schedule
Every week, we release lessons on new science topics. To look for the latest content releases, visit the “Recently Added” section in the app.
Week of June 21, 2021 — 4 NEW Lessons:
Week of June 14, 2021 — 12 NEW Lessons:
Week of June 7, 2021 — 12 NEW Lessons:
Week of May 23, 2021 — 8 NEW Lessons:
Week of May 17, 2021 — 8 NEW Lessons:
Week of May 10, 2021 — 7 NEW Lessons:
Week of May 3, 2021 — 8 NEW Lessons:
Week of April 26, 2021 — 12 NEW Lessons:
Week of April 19, 2021 — 8 NEW Lessons: